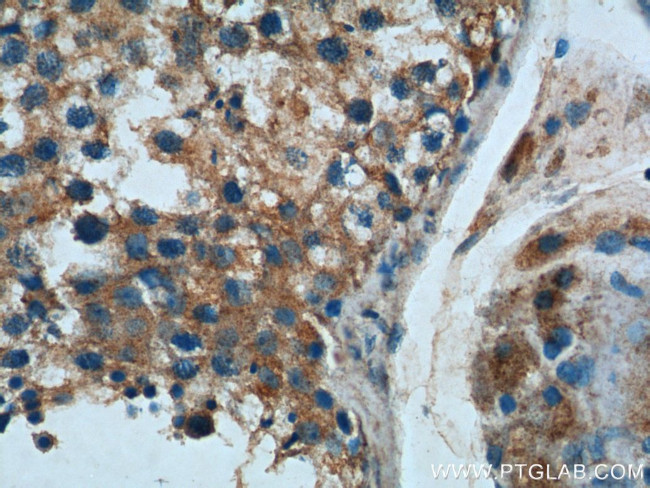
C1orf9 Antibody in Immunohistochemistry (Paraffin) (IHC (P))
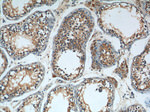
C1orf9 Antibody in Immunohistochemistry (Paraffin) (IHC (P))

Search
Proteintech
C1orf9 Polyclonal Antibody
{{$productOrderCtrl.translations['antibody.pdp.commerceCard.promotion.promotions']}}
{{$productOrderCtrl.translations['antibody.pdp.commerceCard.promotion.viewpromo']}}
{{$productOrderCtrl.translations['antibody.pdp.commerceCard.promotion.promocode']}}: {{promo.promoCode}} {{promo.promoTitle}} {{promo.promoDescription}}. {{$productOrderCtrl.translations['antibody.pdp.commerceCard.promotion.learnmore']}}
产品信息
26074-1-AP
种属反应
宿主/亚型
分类
类型
抗原
偶联物
形式
浓度
规格
纯化类型
保存液
内含物
保存条件
运输条件
产品详细信息
Immunogen sequence: GNLVHGSNQ KESVFMRLNN RIKALEVNMS LSGRYLEELS QRYRKQMEEM QKAFNKTIVK LQNTSRIAEE QDQRQTEAIQ LLQAQLTNMT QLVSNLSATV AELKREVSDR QSYLVISLVL CVVLGLMLCM QRCRNTSQFD GDYISKLPKS NQYPSPKRCF SSYDDMNLKR RTSFPLMRSK SLQLTGKEVD PNDLYIVEPL KFSPEKKKKR CKYKIEKIET IKPEEPLHPI ANGDIKGRKP FTNQRDFSNM GEVYHSSYKG PPSEGSSETS SQSEESYFCG ISACTSLCNG QSQKTKTEKR ALKRRRSKVQ DQGKLIKTLI QTKSGSLPSL HDIIKGNKEI TVGTFGVTAV SGHI (902-1254 aa encoded by BC137125)
仅用于科研。不用于诊断过程。未经明确授权不得转售。
篇参考文献 (0)
生物信息学
蛋白别名: Membrane protein CH1; osteopotentia; protein C1orf9 homolog; Protein osteopotentia; Protein osteopotentia homolog; SUN domain-containing ossification factor; SUN-like protein 1; unnamed protein product
基因别名: 4732491B11; AI848100; AU016931; C1orf9; CH1; OPT; SLP1; SUCO
UniProt ID: (Human) Q9UBS9, (Mouse) Q8C341
Entrez Gene ID: (Human) 51430, (Mouse) 226551